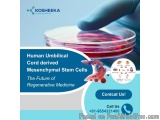

Ad in: Noida, India - Health & Wellness
Human Umbilical Cord derived Mesenchymal Stem Cells: The Future of Regenerative Medicine - Price: Rs. 0
Ad # 930748
Stem cells have opened up new avenues in treatment. With their regenerative potential, they have transformed into the cure for many degenerative diseases with no cure in sight. Leading the charge for these treatments are human umbilical cord-derived mesenchymal stem cells. Their easy and noninvasive collection, in addition to their high regenerative potential, has promoted their use in research and therapies. They have become a part of the clinical trials for diabetes, neurological disorders, damage, eye disorders, and many more. The human umbilical cord-derived stem cell treatment still requires standardisation of the process and further research into their mechanism.
Accelerate the clinical translation of stem cell therapy with Kosheeka’s Human Umbilical Cord derived Mesenchymal Stem Cells.They are isolated in aseptic conditions following a GMP-compliant process in a BSL-2 laboratory. Order today at +91-9654321400.
Your message has been sent
Accelerate the clinical translation of stem cell therapy with Kosheeka’s Human Umbilical Cord derived Mesenchymal Stem Cells.They are isolated in aseptic conditions following a GMP-compliant process in a BSL-2 laboratory. Order today at +91-9654321400.